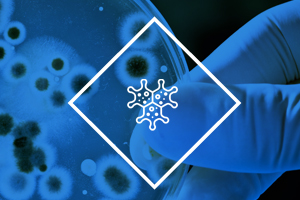

Atención a empresas
Análisis clínicos para el personal operatativo
Si estás buscando personal y asegurarse que las personas que se contraten sean las indicadas no es una tarea fácil. Los estudios adecuados para la selección de personal es imprescindible para la toma de decisión del candidato.
En la selección del personal es normal que quieras saber su estado de salud, o si consume algún tipo de droga de abuso.
Cerciórate de una vez y disminuye:
-Accidentes Laborales y enfermedades
-Ausentismo
-Incapacidades
-Distribución de Personal